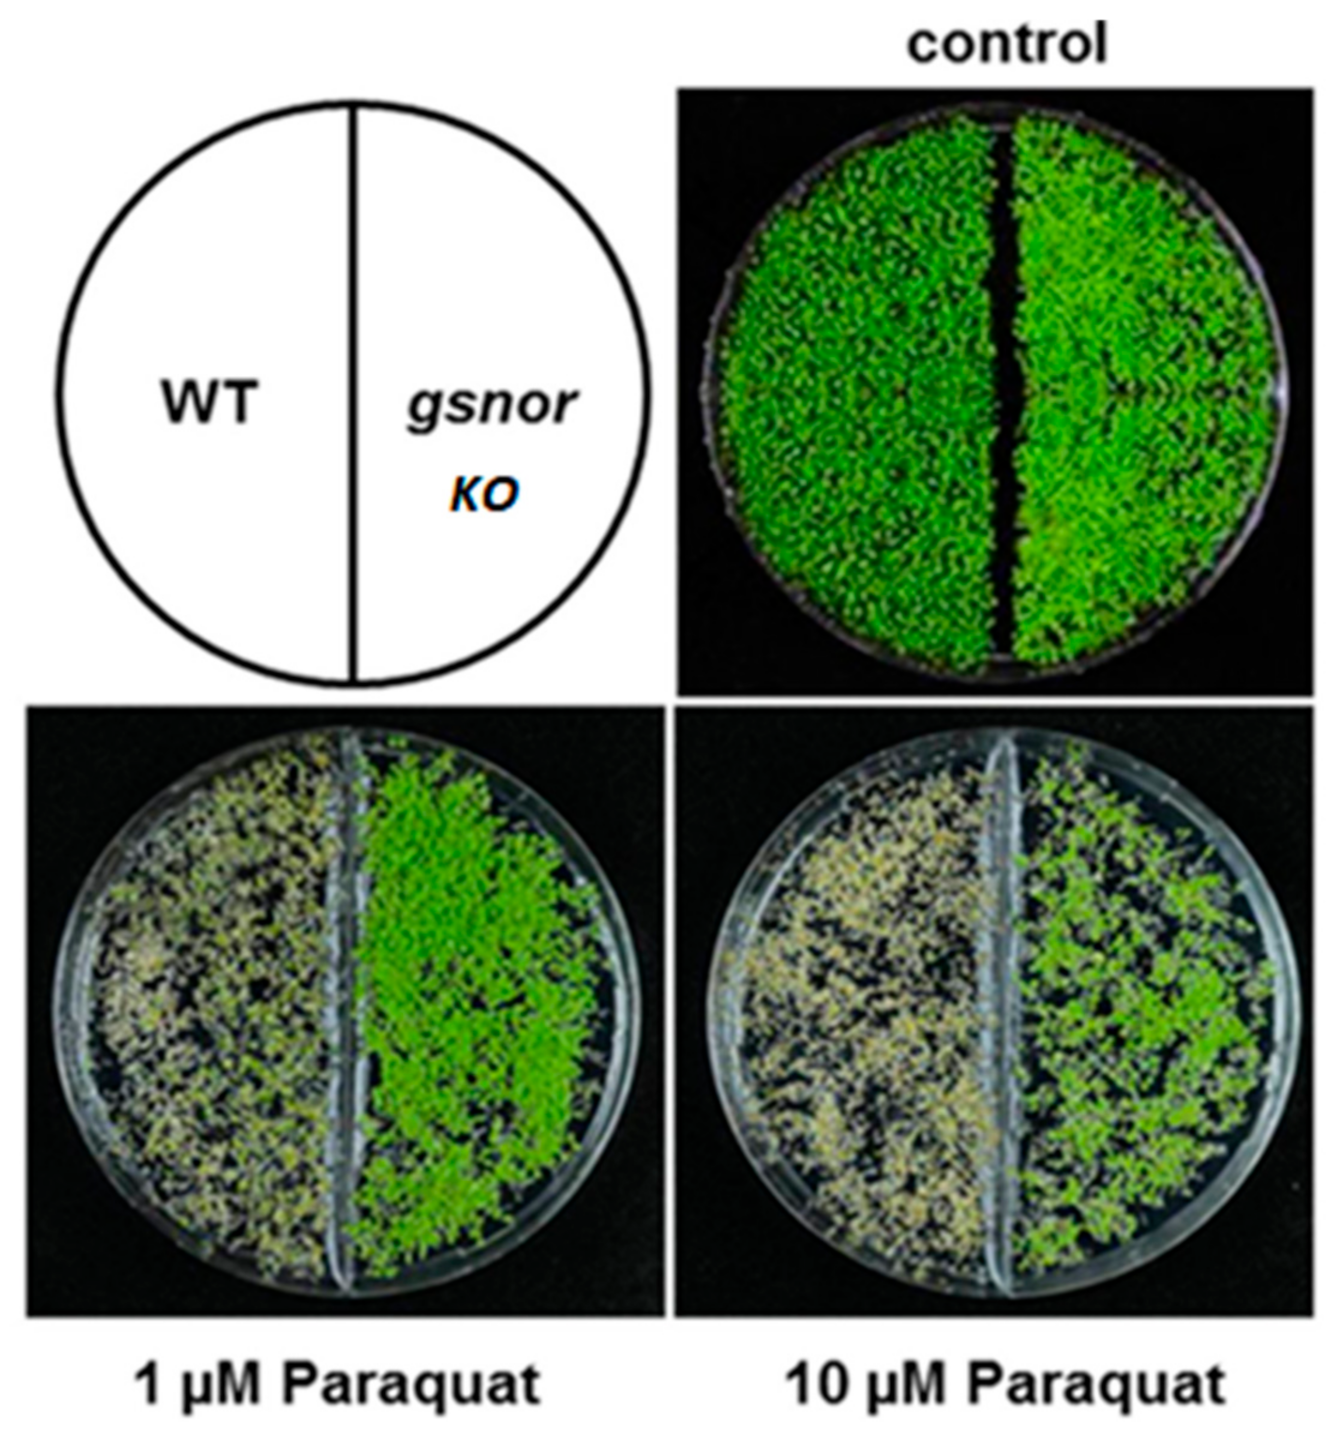
Antioxidants 09 01206 g005

The Physiological Implications of S-Nitrosoglutathione Reductase (GSNOR) Activity Mediating NO Signalling in Plant Root Structures
Abstract
:1. Introduction
2. Root Development in Response to Changes in Nutrient Availability
3. The Role of Nitric Oxide in Plant Biology
4. GSNOR Activity is Related to NO Production
5. Strong Oxidizing Agents are Capable of Reducing GSNOR Activity
6. Auxin is an Important Hormone Capable of Mediating Cellular Growth in Concert with GSNOR
7. Interplay between Strigolactones and NO
8. Conclusions
Author Contributions
Funding
Conflicts of Interest
References
- Shi, Y.-F.; Wang, D.-L.; Wang, C.; Culler, A.H.; Kreiser, M.A.; Suresh, J.; Cohen, J.D.; Pan, J.; Baker, B.; Liu, J.-Z. Loss of GSNOR1 Function Leads to Compromised Auxin Signaling and Polar Auxin Transport. Mol. Plant 2015, 8, 1350–1365. [Google Scholar] [CrossRef] [Green Version]
- Begara-Morales, J.C.; Chaki, M.; Valderrama, R.; Sánchez-Calvo, B.; Mata-Pérez, C.; Padilla, M.N.; Corpas, F.J.; Barroso, J.B. Nitric oxide buffering and conditional nitric oxide release in stress response. J. Exp. Bot. 2018, 69, 3425–3438. [Google Scholar] [CrossRef]
- Jahnová, J.; Luhová, L.; Petřivalský, M. S-Nitrosoglutathione Reductase—The Master Regulator of Protein S-Nitrosation in Plant NO Signaling. Plants 2019, 8, 48. [Google Scholar] [CrossRef] [Green Version]
- Forman, H.J.; Zhang, H.; Rinna, A. Glutathione: Overview of its protective roles, measurement, and biosynthesis. Mol. Asp. Med. 2009, 30, 1–12. [Google Scholar] [CrossRef] [PubMed] [Green Version]
- Salgado, I.; Martinez, C.; Oliveira, H.; Frungillo, L. Nitric oxide signaling and homeostasis in plants: A focus on nitrate reductase and S-nitrosoglutathione reductase in stress-related responses. Braz. J. Bot. 2013, 36. [Google Scholar] [CrossRef]
- Kubienová, L.; Kopečný, D.; Tylichová, M.; Briozzo, P.; Skopalová, J.; Šebela, M.; Navrátil, M.; Tâche, R.; Luhová, L.; Barroso, J.B.; et al. Structural and functional characterization of a plant S-nitrosoglutathione reductase from Solanum lycopersicum. Biochimie 2013, 95, 889–902. [Google Scholar] [CrossRef] [PubMed]
- López-Bucio, J.; Cruz-Ramírez, A.; Herrera-Estrella, L. The role of nutrient availability in regulating root architecture. Curr. Opin. Plant Biol. 2003, 6, 280–287. [Google Scholar] [CrossRef]
- Correa-Aragunde, N.; Cejudo, F.J.; Lamattina, L. Nitric oxide is required for the auxin-induced activation of NADPH-dependent thioredoxin reductase and protein denitrosylation during root growth responses in arabidopsis. Ann. Bot. 2015, 116, 695–702. [Google Scholar] [CrossRef] [Green Version]
- Remans, T.; Nacry, P.; Pervent, M.; Girin, T.; Tillard, P.; Lepetit, M.; Gojon, A. A Central Role for the Nitrate Transporter NRT2.1 in the Integrated Morphological and Physiological Responses of the Root System to Nitrogen Limitation in Arabidopsis. Plant Physiol. 2006, 140, 909–921. [Google Scholar] [CrossRef] [Green Version]
- Dordas, C. Role of nutrients in controlling plant diseases in sustainable agriculture. A review. Agron. Sustain. Dev. 2008, 28, 33–46. [Google Scholar] [CrossRef] [Green Version]
- Hussain, A.; Yun, B.-W.; Kim, J.H.; Gupta, K.J.; Hyung, N.-I.; Loake, G.J. Novel and conserved functions of S-nitrosoglutathione reductase in tomato. J. Exp. Bot. 2019, 70, 4877–4886. [Google Scholar] [CrossRef] [PubMed]
- Gong, B.; Wen, D.; Wang, X.; Wei, M.; Yang, F.; Li, Y.; Shi, Q. S-Nitrosoglutathione Reductase-Modulated Redox Signaling Controls Sodic Alkaline Stress Responses in Solanum lycopersicum L. Plant Cell Physiol. 2015, 56, 790–802. [Google Scholar] [CrossRef] [PubMed] [Green Version]
- Yun, B.-W.; Skelly, M.J.; Yin, M.; Yu, M.; Mun, B.-G.; Lee, S.-U.; Hussain, A.; Spoel, S.H.; Loake, G.J. Nitric oxide and S-nitrosoglutathione function additively during plant immunity. New Phytol. 2016, 211, 516–526. [Google Scholar] [CrossRef] [PubMed] [Green Version]
- García, M.J.; Corpas, F.J.; Lucena, C.; Alcántara, E.; Pérez-Vicente, R.; Zamarreño, Á.M.; Bacaicoa, E.; García-Mina, J.M.; Bauer, P.; Romera, F.J. A Shoot Fe Signaling Pathway Requiring the OPT3 Transporter Controls GSNO Reductase and Ethylene in Arabidopsis thaliana Roots. Front. Plant Sci. 2018, 9. [Google Scholar] [CrossRef]
- Li, B.; Sun, L.; Huang, J.; Göschl, C.; Shi, W.; Chory, J.; Busch, W. GSNOR provides plant tolerance to iron toxicity via preventing iron-dependent nitrosative and oxidative cytotoxicity. Nat. Commun. 2019, 10. [Google Scholar] [CrossRef]
- Linkohr, B.I.; Williamson, L.C.; Fitter, A.H.; Leyser, H.M.O. Nitrate and phosphate availability and distribution have different effects on root system architecture of Arabidopsis. Plant J. 2002, 29, 751–760. [Google Scholar] [CrossRef] [Green Version]
- Nordström, A.; Tarkowski, P.; Tarkowska, D.; Norbaek, R.; Åstot, C.; Dolezal, K.; Sandberg, G. Auxin regulation of cytokinin biosynthesis in Arabidopsis thaliana: A factor of potential importance for auxin–cytokinin-regulated development. Proc. Natl. Acad. Sci. USA 2004, 101, 8039–8044. [Google Scholar] [CrossRef] [Green Version]
- Zhang, H.; Jennings, A.; Barlow, P.W.; Forde, B.G. Dual pathways for regulation of root branching by nitrate. Proc. Natl. Acad. Sci. USA 1999, 96, 6529–6534. [Google Scholar] [CrossRef] [Green Version]
- Rockel, P.; Strube, F.; Rockel, A.; Wildt, J.; Kaiser, W.M. Regulation of nitric oxide (NO) production by plant nitrate reductase in vivo and in vitro. J. Exp. Bot. 2002, 53, 103–110. [Google Scholar] [CrossRef]
- Sanz, L.; Albertos, P.; Mateos, I.; Sánchez-Vicente, I.; Lechón, T.; Fernández-Marcos, M.; Lorenzo, O. Nitric oxide (NO) and phytohormones crosstalk during early plant development. J. Exp. Bot. 2015, 66, 2857–2868. [Google Scholar] [CrossRef]
- Rustérucci, C.; Espunya, M.C.; Díaz, M.; Chabannes, M.; Martínez, M.C. S-Nitrosoglutathione Reductase Affords Protection against Pathogens in Arabidopsis, Both Locally and Systemically. Plant Physiol. 2007, 143, 1282–1292. [Google Scholar] [CrossRef] [PubMed] [Green Version]
- Chamizo-Ampudia, A.; Sanz-Luque, E.; Llamas, A.; Galvan, A.; Fernández, E. Nitrate Reductase Regulates Plant Nitric Oxide Homeostasis. Trends Plant Sci. 2017, 22, 163–174. [Google Scholar] [CrossRef] [PubMed]
- Cookson, S.J.; Williams, L.E.; Miller, A.J. Light-Dark Changes in Cytosolic Nitrate Pools Depend on Nitrate Reductase Activity in Arabidopsis Leaf Cells. Plant Physiol. 2005, 138, 1097–1105. [Google Scholar] [CrossRef] [PubMed] [Green Version]
- Corpas, F.J.; Palma, J.M.; Río, L.A.D.; Barroso, J.B. Evidence supporting the existence of l-arginine-dependent nitric oxide synthase activity in plants. New Phytol. 2009, 184, 9–14. [Google Scholar] [CrossRef]
- Gupta, K.J.; Kaiser, W.M. Production and Scavenging of Nitric Oxide by Barley Root Mitochondria. Plant Cell Physiol. 2010, 51, 576–584. [Google Scholar] [CrossRef] [Green Version]
- Chamizo-Ampudia, A.; Sanz-Luque, E.; Llamas, Á.; Ocaña-Calahorro, F.; Mariscal, V.; Carreras, A.; Barroso, J.B.; Galván, A.; Fernández, E. A dual system formed by the ARC and NR molybdoenzymes mediates nitrite-dependent NO production in Chlamydomonas. Plant Cell Environ. 2016, 39, 2097–2107. [Google Scholar] [CrossRef]
- Jeandroz, S.; Wipf, D.; Stuehr, D.J.; Lamattina, L.; Melkonian, M.; Tian, Z.; Zhu, Y.; Carpenter, E.J.; Wong, G.K.-S.; Wendehenne, D. Occurrence, structure, and evolution of nitric oxide synthase–like proteins in the plant kingdom. Sci. Signal. 2016, 9, re2. [Google Scholar] [CrossRef] [Green Version]
- Foresi, N.; Correa-Aragunde, N.; Parisi, G.; Caló, G.; Salerno, G.; Lamattina, L. Characterization of a nitric oxide synthase from the plant kingdom: NO generation from the green alga Ostreococcus tauri is light irradiance and growth phase dependent. Plant Cell 2010, 22, 3816–3830. [Google Scholar] [CrossRef] [Green Version]
- Gaupels, F.; Kuruthukulangarakoola, G.T.; Durner, J. Upstream and downstream signals of nitric oxide in pathogen defence. Curr. Opin. Plant Biol. 2011, 14, 707–714. [Google Scholar] [CrossRef]
- Frungillo, L.; Skelly, M.J.; Loake, G.J.; Spoel, S.H.; Salgado, I. S-nitrosothiols regulate nitric oxide production and storage in plants through the nitrogen assimilation pathway. Nat. Commun. 2014, 5, 5401. [Google Scholar] [CrossRef] [Green Version]
- Mur, L.A.J.; Mandon, J.; Persijn, S.; Cristescu, S.M.; Moshkov, I.E.; Novikova, G.V.; Hall, M.A.; Harren, F.J.M.; Hebelstrup, K.H.; Gupta, K.J. Nitric oxide in plants: An assessment of the current state of knowledge. AoB Plants 2012, 5. [Google Scholar] [CrossRef] [PubMed]
- Kolesnik, B.; Heine, C.L.; Schmidt, R.; Schmidt, K.; Mayer, B.; Gorren, A.C.F. Aerobic nitric oxide-induced thiol nitrosation in the presence and absence of magnesium cations. Free Radic. Biol. Med. 2014, 76, 286–298. [Google Scholar] [CrossRef] [PubMed] [Green Version]
- Kovacs, I.; Lindermayr, C. Nitric oxide-based protein modification: Formation and site-specificity of protein S-nitrosylation. Front. Plant Sci. 2013, 4, 137. [Google Scholar] [CrossRef] [PubMed] [Green Version]
- Laugier, E.; Bouguyon, E.; Mauriès, A.; Tillard, P.; Gojon, A.; Lejay, L. Regulation of High-Affinity Nitrate Uptake in Roots of Arabidopsis Depends Predominantly on Posttranscriptional Control of the NRT2.1/NAR2.1 Transport System. Plant Physiol. 2012, 158, 1067–1078. [Google Scholar] [CrossRef] [PubMed] [Green Version]
- Skelly, M.J.; Loake, G.J. Synthesis of Redox-Active Molecules and Their Signaling Functions During the Expression of Plant Disease Resistance. Antioxid. Redox Signal. 2013, 19, 990–997. [Google Scholar] [CrossRef] [Green Version]
- Guerra, D.; Ballard, K.; Truebridge, I.; Vierling, E. S-nitrosation of conserved cysteines modulates activity and stability of S-nitrosoglutathione reductase (GSNOR). Biochemistry 2016, 55, 2452–2464. [Google Scholar] [CrossRef] [Green Version]
- Tichá, T.; Lochman, J.; Činčalová, L.; Luhová, L.; Petřivalský, M. Redox regulation of plant S-nitrosoglutathione reductase activity through post-translational modifications of cysteine residues. Biochem. Biophys. Res. Commun. 2017, 494, 27–33. [Google Scholar] [CrossRef]
- Kovacs, I.; Holzmeister, C.; Wirtz, M.; Geerlof, A.; Fröhlich, T.; Römling, G.; Kuruthukulangarakoola, G.T.; Linster, E.; Hell, R.; Arnold, G.J.; et al. ROS-Mediated Inhibition of S-nitrosoglutathione Reductase Contributes to the Activation of Anti-oxidative Mechanisms. Front. Plant Sci. 2016, 7. [Google Scholar] [CrossRef] [Green Version]
- Gong, B.; Yan, Y.; Zhang, L.; Cheng, F.; Liu, Z.; Shi, Q. Unravelling GSNOR-Mediated S-Nitrosylation and Multiple Developmental Programs in Tomato Plants. Plant Cell Physiol. 2019, 60, 2523–2537. [Google Scholar] [CrossRef]
- Del Río, L.A. ROS and RNS in plant physiology: An overview. J. Exp. Bot. 2015, 66, 2827–2837. [Google Scholar] [CrossRef] [Green Version]
- Lymperopoulos, P.; Msanne, J.; Rabara, R. Phytochrome and Phytohormones: Working in Tandem for Plant Growth and Development. Front. Plant Sci. 2018, 9. [Google Scholar] [CrossRef] [PubMed] [Green Version]
- París, R.; Iglesias, M.J.; Terrile, M.C.; Casalongué, C.A. Functions of S-nitrosylation in plant hormone networks. Front. Plant Sci. 2013, 4. [Google Scholar] [CrossRef] [PubMed] [Green Version]
- Dharmasiri, N.; Dharmasiri, S.; Estelle, M. The F-box protein TIR1 is an auxin receptor. Nature 2005, 435, 441–445. [Google Scholar] [CrossRef]
- Terrile, M.C.; París, R.; Calderón-Villalobos, L.I.A.; Iglesias, M.J.; Lamattina, L.; Estelle, M.; Casalongué, C.A. Nitric oxide influences auxin signaling through S-nitrosylation of the Arabidopsis TRANSPORT INHIBITOR RESPONSE 1 auxin receptor. Plant J. 2012, 70, 492–500. [Google Scholar] [CrossRef] [PubMed] [Green Version]
- Kleine-Vehn, J.; Ding, Z.; Jones, A.R.; Tasaka, M.; Morita, M.T.; Friml, J. Gravity-induced PIN transcytosis for polarization of auxin fluxes in gravity-sensing root cells. Proc. Natl. Acad. Sci. USA 2010, 107, 22344–22349. [Google Scholar] [CrossRef] [PubMed] [Green Version]
- Overvoorde, P.; Fukaki, H.; Beeckman, T. Auxin Control of Root Development. Cold Spring Harb. Perspect. Biol. 2010, 2, a001537. [Google Scholar] [CrossRef] [Green Version]
- Nisar, N.; Li, L.; Lu, S.; Khin, N.C.; Pogson, B.J. Carotenoid Metabolism in Plants. Mol. Plant 2015, 8, 68–82. [Google Scholar] [CrossRef] [Green Version]
- Kolbert, Z. Strigolactone-nitric oxide interplay in plants: The story has just begun. Physiol. Plant. 2019, 165, 487–497. [Google Scholar] [CrossRef]
- Oláh, D.; Feigl, G.; Molnár, Á.; Ördög, A.; Kolbert, Z. Strigolactones Interact With Nitric Oxide in Regulating Root System Architecture of Arabidopsis thaliana. Front. Plant Sci. 2020, 11. [Google Scholar] [CrossRef]
- Marquez-Garcia, B.; Njo, M.; Beeckman, T.; Goormachtig, S.; Foyer, C.H. A new role for glutathione in the regulation of root architecture linked to strigolactones. Plant Cell Environ. 2014, 37, 488–498. [Google Scholar] [CrossRef]

Publisher’s Note: MDPI stays neutral with regard to jurisdictional claims in published maps and institutional affiliations. |
© 2020 by the authors. Licensee MDPI, Basel, Switzerland. This article is an open access article distributed under the terms and conditions of the Creative Commons Attribution (CC BY) license (http://creativecommons.org/licenses/by/4.0/).
Share and Cite
Ventimiglia, L.; Mutus, B. The Physiological Implications of S-Nitrosoglutathione Reductase (GSNOR) Activity Mediating NO Signalling in Plant Root Structures. Antioxidants 2020, 9, 1206. https://doi.org/10.3390/antiox9121206
Ventimiglia L, Mutus B. The Physiological Implications of S-Nitrosoglutathione Reductase (GSNOR) Activity Mediating NO Signalling in Plant Root Structures. Antioxidants. 2020; 9(12):1206. https://doi.org/10.3390/antiox9121206
Chicago/Turabian StyleVentimiglia, Leslie, and Bulent Mutus. 2020. "The Physiological Implications of S-Nitrosoglutathione Reductase (GSNOR) Activity Mediating NO Signalling in Plant Root Structures" Antioxidants 9, no. 12: 1206. https://doi.org/10.3390/antiox9121206




